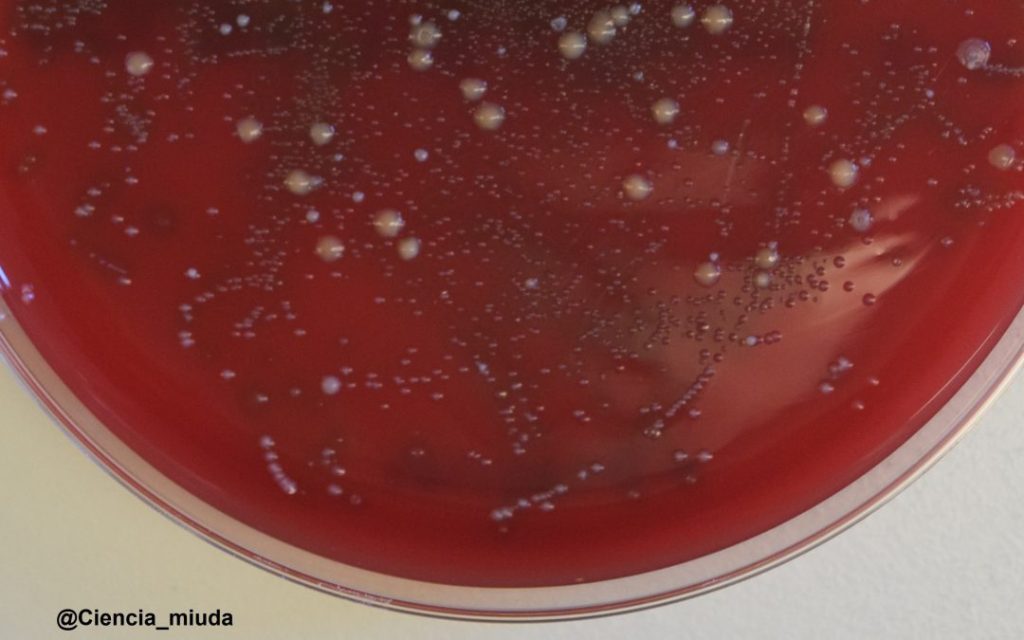

Sección de tema neurocientífico en una radio

- El apartado de neurociencia de hoy va a ser algo diferente, ya que en esta ocasión vamos a empezar hablando con nuestra experta sobre las bacterias de nuestra vida.
- ¡Pues si! Me gustaría empezar esta sección de neurociencia hablando de microorganismos porque, aunque parezca mentira, según qué virus, qué bacterias, qué hongos y demás seres microscópicos decidan vivir sobre nosotros y dentro nuestra va a depender nuestra salud. Esto se debe a que estos diminutos seres (que nos acompañan a lo largo de toda nuestra vida) van a influir fuertemente en el desarrollo de nuestro sistema inmune y en nuestras funciones metabólicas. En cada uno de nosotros vive una combinación única de microorganismos, que empieza a formarse durante el nacimiento (algunos dices que incluso antes), se aumenta con la lactancia y se va modificando a lo largo de toda nuestra vida. Además, también hay otros factores que influyen en gran medida en que bacterias van a decidir quedarse q vivir con nosotros: como la edad, nuestro sexo, o nuestra forma de vivir.
- ¿Y en qué parte del cuerpo se encuentran estos microorganismos, al parecer, tan importantes para nuestra salud?
- Prácticamente todas las partes de nuestro cuerpo, por supuesto con algunas excepciones, están habitadas por virus, bacteria y el resto de microorganismos. Pero donde mayor cantidad de ellos hay es en nuestro tracto gastrointestinal, sobretodo en el intestino. De hecho, el conjunto de todos las bacterias que viven en nuestro intestino recibe el nombre de microbiota intestinal y hoy en día sabemos que esta microbiota intestina juega un papel importantísimo en la salud humana.
- Pero, este es un apartado de neurociencia… ¿qué tiene esto que ver las bacterias de nuestro intestino con la neurociencia?
- Pues mucho más de lo que podría parecer en un principio. Me explico. Por un lado, se ha visto que la dieta (entendiendo dieta como nuestros hábitos alimenticios, no como un régimen específico) afecta a algunos aspectos de la función cerebral y del comportamiento. Este efecto de la dieta sobre nuestro cerebro se produce a través de la influencia de la microbiota intestinal (las bacterias del intestino), ya que el intestino tiene una red neuronal muy extensa que no solo facilita la comunicación, sino que hace posible una continua interacción con el sistema nervioso central. Además, en los últimos años los investigadores nos hemos dado cuenta de la importancia de la microbiota intestinal lo que ha hecho que se amplíe el concepto del eje intestino-cerebro, lo que puede ser bastante relevante para el desarrollo de terapias y tratamientos relacionados con la salud mental y ciertas enfermedades neurológicas.

- Has mencionado el concepto del eje intestino-cerebro, que no había oído nunca, ¿podrías explicar un poco de qué se trata?
- Tradicionalmente se ha aceptado que el cerebro es capaz de modular diferentes sistemas del organismo, entre ellos el sistema gastrointestinal. En este sentido, Las primeras observaciones directas sobre este hecho que datan de finales del siglo XIX. están basadas en que los estados emocionales podían alterar el tipo de secreción gástrica o el ritmo intestinal. Pero hoy en día en neurociencia ya se utiliza el término eje intestino-cerebroque es una conexión bidireccional de información que se produce entre los sistemas neuroinmune, neuroendocrino con varios sistemas nerviosos: 1) el sistema nervioso central, 2) el sistema nervioso autónomo y 3) el sistema nervioso entérico; que se realiza a través de la activación sensorial de nervios aferentes y eferentes del nervio vago. Por si fuera poco, desde hace algún tiempo se habla ya y por eso quería empezar hablando de las bacterias del intestino del eje microbiota-intestino-cerebro por el cual estas bacterias afectan a nuestro comportamiento, pero a la vez cambios en la conducta también modifican nuestras bacterias.
- Entonces, ¿ya se sabe que hay enfermedades que son producidas por las bacterias de nuestro intestino?
- Pues sí, ya se sabe que algunas patologías se producen como consecuencia de alteraciones en la composición de nuestras bacterias intestinales, que es lo que los científicos llamamos disbiosis. Durante esta disbiosis aumenta la cantidad de ciertas de la microbiota intestinal. Algunas de estas bacterias producen ciertos neurotransmisores que, a través del nervio vago, inducen la activación de procesos inmunoinflamatorios y de estrés oxidativo así como mecanismos neuromoduladores y procesos epigenéticos. Todo esto llega al sistema neuroendocrino y al sistema nerviosos central alterando nuestro comportamiento.
- ¿Por qué se producen estas alteraciones en las bacterias de nuestro intestino que tan mal nos sientan?
- Estos cambios en la composición normal de la microbiota están normalmente producidos por aspectos de la vida moderna actual como tener nuevos hábitos alimenticios, hacer un uso masivo de compuestos antibióticos o estar continuamente sufriendo de estrés continuo. Todos estos factores de nuestra vida pueden afectar al movimiento y a las secreciones de los intestinos y producir también hipersensibilidad visceral. Incluso, como en ocasiones la disbiosis también afecta a células neuroendocrinas y células del sistema inmune se pueden producir diferentes manifestaciones psiquiátricas.

- Y a parte del gusto por el saber, ¿conocer estas cosas sirve para algo?
- ¡Por supuesto! Gracias a estudios realizados en animales sin bacterias intestinales hemos comprobado que estas juegan un papel clave en el buen funcionamiento del sistema inmune y del sistema digestivo. Además, también son necesarias para un buen funcionamiento de los mecanismos de respuesta al estrés y la ansiedad, y para el mantenimiento de funciones cognitivas (como la memoria). De hecho, se ha demostrado que el trasplante de material fecal de pacientes con trastornos psiquiátricos a ratas sin bacterias intestinales puede inducir en estos animales síntomas psiquiátricos. Además, parece que dos enfermedades como son el Síndrome de Colon Irritable y la Enfermedad Inflamatoria Intestinal se deben a una mala comunicación dentro del eje microbiota-intestino-cerebro. Para intentar tratarlas se están probando nuevas terapias a través intervenciones nutricionales y suplementos de probióticos específicos con los que están obteniendo buenos resultados. Las investigaciones en los modelos preclínicos sugieren que el efecto de las bacterias en el comportamiento quizás podría estar más relacionado con cambios en la amígdala y en el hipocampo.
- ¿Se podría utilizar bacterias para tratar enfermedades neurológicas?
- Pues estamos trabajando en ello. A partir del estudio del eje microbiota-intestino-cerebro, se está intentando abrir una nueva línea de opciones terapéuticas en este tipo de enfermedades. Por ejemplo: 1) el uso de probióticos que son microorganismos vivos que, cuando se ingieren en las cantidades adecuadas, pueden aportar beneficios para la salud de quien los consume; 2) el uso de prebióticos, compuestos obtenidos de microorganismos que el nuestro cuerpo no puede digerir, pero que tienen un efecto fisiológico en el intestino al estimular, de manera selectiva, el crecimiento y la actividad de las bacterias beneficiosas; 3) el uso de compuesto antibióticos.
- ¿Qué tipo de trastornos neurológicos se podrían tratar con este tipo de terapias que emplean bacterias para producir neurotransmisores?
- Pues los datos parecen indicar que este nuevo tipo de terapias sería útil para tratar enfermedades tan comunes como la depresión, el autismo o el TDH. Incluso algunos estudios muestran su potencial para tratar enfermedades neurodegenerativas como son el Parkinson o el Alzheimer. Muchas de las terapias de vanguardia para los trastornos cerebrales tienen como objetivo restablecer la neurotransmisión en las áreas cerebrales afectadas, y es que dado que algunas bacterias pueden producir grandes cantidades de neurotransmisores (como la acetilcolina y la serotonina) la idea es de utilizar estos microorganismos para producir estos compuestos como terapia y tratar los trastornos neurológicos.

- ¿Entonces estamos ante la posible cura de todas estas enfermedades?
- Desgraciadamente aún es muy pronto para hablar de cura. Aun no nos encontramos en ese punto. Pero sí que estamos avanzando mucho. Lo primero que se debe hacer para poder tratar y/o curar una enfermedad es comprenderla por completo. Y es que, a pesar de todos los grandes adelantos en relación a este tema de los últimos años, a la hora de hablar del eje microbiota-intestino-cerebro todavía nos movemos en un campo relativamente nuevo. Aun no conocemos de forma exacta como se produce la comunicación bidireccional del eje microbiota-intestino-cerebro. Es muy difícil avanzar en este tema ya que los estudios en humanos son muy escasos, viniendo la mayor parte de la información de estudios hecho con animales que, aunque es una primera aproximación no es lo ideal. Además, siempre existe la duda de si es la disbiosis la que causa los trastornos neurológicos o si es al revés. Y, por último, pero no por ello menos importante, hay que tener en cuenta en cada uno tenemos una microbiota intestinal única por lo que tanto los diagnósticos como los tratamientos deberían de hacerse en función de cada paciente.
